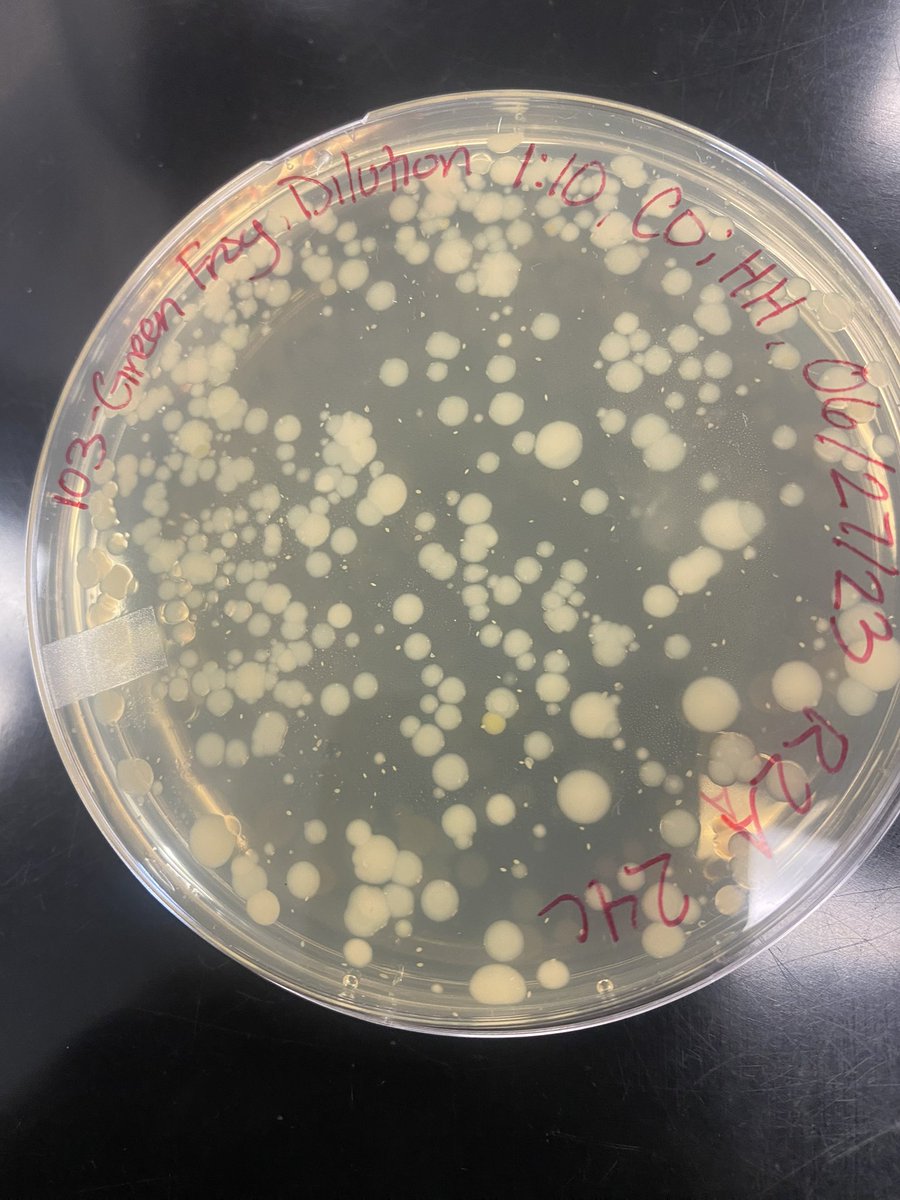
We have completed week 1 of Gene Team, and the students have been hard at work! It’s been a great start to a very interesting project from the <a href="/RZ_Lab/">RZ Amphibian Lab</a>!

Corinne Zawacki
@cori_zawacki
Biologist, frog nerd, and mommy
ID: 875176801445838848
15-06-2017 02:23:04
768 Tweet
781 Followers
262 Following

Check out our new JEB paper, led by Michel E B Ohmer ! Frogs, climate change, behavior, and more. 🐸💚

Join us on Tuesday 6/6 at the Pymatuning Lab of Ecology dining hall (11758 Fries Rd.) at 7pm for a talk by Chris Tracey of NatureServe about his work using biodiversity data to inform conservation decisions.



We have completed week 1 of Gene Team, and the students have been hard at work! It’s been a great start to a very interesting project from the RZ Amphibian Lab!

The Gene Team had a very busy day of experiments! They are working on a project from the RZ Amphibian Lab to identify bacteria from frog slime and test if it can inhibit fungal growth. They’ve already made great progress and we can’t wait to see all of their data and conclusions!


Student volunteers from Pymatuning Lab of Ecology conducted outreach at the Linesville Onion Festival where visitors of all ages learned about life at the organismal, cellular, and molecular levels using microscopy and DNA extractions! 🧅 ↔️ 🧬 #SciComm

Join us on Tuesday 7/18 at 7pm in the Pymatuning Lab of Ecology dining hall for a seminar by Taylor Zallek entitled "Using experimental evolutionary ecology to understand biological invasions"



Summer teacher workshop 2023: Duckweed Dynamics with @Exp_EvoEco. It was so nice to be back at Pymatuning Lab of Ecology working with awesome high school teachers!



It's here! Our 2023 symposium on a diverse, inclusive, and safe future for field biology is out in ICB's newest issue! Check it out! @r_verble Corinne Zawacki Al_Troutman M.Sc. Shayle B Matsuda, Ph.D. Amy-Charlotte Devitz @n_morales83 Maryam K Dr.Itumeleng Moroenyane 🇿🇦🏳️🌈 Elizabeth Rudzki Lara Roketenetz

Tonight the Pymatuning Lab of Ecology Summer Undergraduate Research Program participants presented their findings after nine weeks of hard work! It’s been a privilege working with them and I’m amazed at what they’ve accomplished! Thank you to all attendees and Nick for the mocktails!



"Deficits in Accessibility across Field #Research Stations for #Scientists with #Disabilities and/or #chronicillness Illness, and Proposed Solutions" Elizabeth Rudzki & @KevinDKohl doi.org/10.1093/icb/ic… #sciencetwitter #biologists #DisabledInStem



now out in MBE Oxford Academic Society for Molecular Biology and Evolution doi.org/10.1093/molbev…

Anyone following the tragic story of the skin-eating fungus 'Bd' devastating amphibian populations knows good news is rare. Now, some frogs in California appear to have evolved resistance to the disease, and years of restoration efforts seem to be working. newscientist.com/article/241167…

Thanks to Roland Knapp UC Santa Barbara for discussing his team's years of work with me. Thanks Corinne Zawacki University of Pittsburgh for insights.

I'm running the half marathon to raise money for GOTR Magee, a program I've helped coach at ECS for 3 years raceroster.com/events/2024/75… via Race Roster






